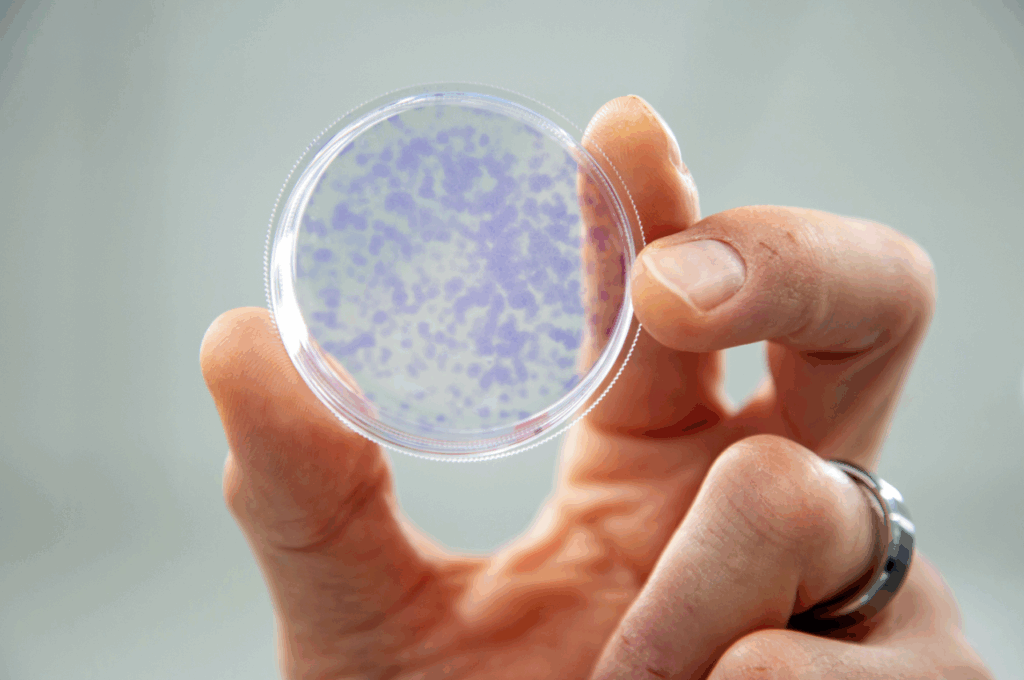
Human cells exposed to radiation from radon. (Photo Credit: Colleen De Neve)

Are you sure you want to do this?
Join the Waitlist
TERMS AND CONDITIONS FOR PARTICIPATION IN THIS RESEARCH:
Research Consent
For all other house types (e.g. apartment), please review our preliminary outcomes here.
|
No Results
|
|
No Results
|